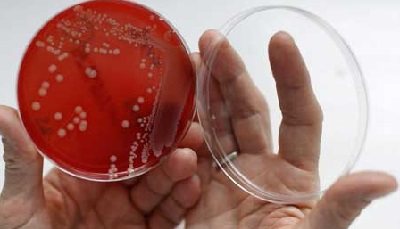

Симптомы гарднереллеза у женщин, основные препараты для лечения Гарднереллез, или бактериальный вагиноз, представляет собой заболевание половых путей, которое характеризуется нарушением нормального состава микрофлоры. В итоге это приводит к преобладанию анаэробных микроорганизмов (они не используют в процессе жизнедеятельности кислород), чего не наблюдается в норме.
Чаще всего встречается гарднереллез у женщин, однако может быть и у мужчин. Частота его у женщин достигает 20-30%, а по некоторым источникам – доходит до 80%.
Симптомы заболевания
Среди признаков гарднереллеза выделяют:
- зуд во влагалище;
- дискомфортные ощущения во время полового акта;
- выраженный неприятный рыбный запах, усиливающийся после занятий сексом и в период менструации;
- боли внизу живота;
- обильные серо-белые и желтоватые выделения из влагалища;
- жжение при мочеиспускании.
Следует отметить, что в 15% случаев возможно отсутствие рыбного запаха, поэтому остальные симптомы нельзя игнорировать.
Одной из особенностей гарднереллеза является наличие воспаления во влагалище и на наружных половых органах. Даже если и диагностируют патологический процесс, то он считается проявлением другого гинекологического заболевания, не связанного с Gardnerella vaginalis.
Как и чем лечить: схемы приема препаратов
Лечение проводится в несколько этапов:
- уничтожение самого возбудителя;
- восстановление микрофлоры во влагалище;
- общая укрепляющая терапия — для повышения иммунитета.
Антибиотики
Первый этап, направленный на подавление патогенной флоры и дальнейшее недопущение ее роста. Важно определить чувствительность гарднерелл к антибиотикам, чтобы лечение прошло успешно.
Основные группы антибиотиков, применяемых в терапии гарднереллеза:
- антибиотики широкого спектра воздействия — Клиндамицин, Метронидазол — убивают виновника болезни и прочие микроорганизмы — стафилококк, кишечную палочку;
- производные имидазолов — Трихопол, Тинидазол — эти препараты губительны в отношении гарднерелл, трихомонад, которые зачастую присоединяются к течению болезни;
- препараты антисептического действия — Макмиррор — действуют мягче, чем антибиотики, но дополнительно препятствует росту грибов во влагалище, предупреждая молочницу.
Антибиотикотерапия составляет в среднем 7-10 дней в дозировках, рассчитанных в зависимости от возраста, веса больных, выраженности воспаления.
Общепринятая дозировка — не менее 500 мг в сутки для препаратов с содержанием метронидазола, трихопола; 300 мг — для Клиндамицина.
При легком и среднем течении болезни возможен разовый прием Метронидазола в объеме 2 г.
Свечи
Применение свечей актуально при незапущенном течении болезни. В основном, суппозитории активно назначают беременным, ведь их плюс — не системное влияние на весь организм, а действие на проблемный очаг — половые пути, влагалище.
Популярные свечи в лечении гарднереллеза:
- Тержинан — комплексный препарат в форме вагинальных таблеток, содержит антимикробные и противогрибковые компоненты;
- Метровагин — содержит метронидазол, губительный по отношению к анаэробной инфекции;
- Гексикон — свечи с содержанием хлоргексидина, который уничтожает вредные микробы, не влияя на лактобактерии;
- Макмиррор в форме свечей — губительно воздействует на условно-патогенные и патогенные микроорганизмы, дополнительно содержит нистатин.
Прочие лекарства
После уничтожения возбудителя важно продолжить лечение медикаментами, которые снимут неприятные симптомы во влагалище и восстановят баланс микрофлоры.
Лактобактерии для в виде свечей или таблеток для употребления внутрь помогут наладить «правильный» биоценоз: пройдут зуд, жжение, неприятные ощущения в животе. Для таких целей назначают:
- Бифидумбактерин в виде лиофилизата;
- Ацилакт в форме свечей;
- Лактобактерин — свечи и порошок.
Курс приема должен быть не менее 14 дней, чаще потребуется месяц, чтобы полезная микрофлора прижилась, поднялся местный иммунитет — в кишечнике и влагалище.
Наиболее эффективны следующие средства:
- Вобэнзим;
- Генферон в свечах;
- Иммунал;
- Интерферон.
Курс — от 10 до 14 дней, после перерыва возможно повторение для лучшего эффекта.
Народные средства
Средства народной медицины безопасны, в основе их действия — травы и растительное сырье с антимикробным и вяжущим эффектом — кора дуба, ромашка, шалфей, череда.
Применяют масла, способные заживлять поврежденную слизистую — оливковое, облепиховое.
Но несмотря на безопасность, лечение без разрешения врача лучше не проводить. Народные способы можно применять в комплексе наряду с лекарственной терапией, для облегчения симптомов.
Уничтожить возбудителя и предотвратить развитие болезни травы и прочие средства из масел, меда не в состоянии.
Популярные рецепты народной медицины в лечении гарднереллеза:
- спринцевание настоем коры дуба (на 10 г сырья 200 мл кипятка) перед сном в течение недели;
- спринцевание настоем из ромашки и подорожника (на 20 г смеси трав стакан кипятка) на ночь, курс — 10 дней;
- тампоны с облепиховым маслом — стерильную марлю пропитать подогретым маслом, свернуть и ввести во влагалище на ночь, курс — 7-10 дней.
Оптимальная продолжительность терапии, лечение партнера
Средняя продолжительность лечения бактериального вагиноза составляет почти 2 месяца, из которых 7-10 дней длится терапия антибиотиками, около 14-30 дней происходит восстановление микрофлоры путем приема биопрепаратов, около 2-х недель нужно для поднятия защитных сил организма.
Сложно лечить — болезнь может возвращаться. При малейших провоцирующих факторах — переохлаждение, стресс — гарднерелла опять начинает активизироваться. Поэтому курсы лекарственной терапии периодически важно повторять.
Мужчинам чаще назначают антимикробные средства в виде мазей и кремов (Метронидазол гель) — они воздействует на очаг воспаления, уничтожая возбудителя. Контрольное обследование важно проводить обоим — женщине и партнеру, при отсутствии в мазке инфекции и клинических проявлений болезнь считается побежденной.
О лечении этого заболевание подробно расскажет врач:
Факторы развития
К основным причинам возникновения гарднереллеза у женщин можно отнести:
- неправильный прием гормональных контрацептивов;
- беспорядочную половую жизнь;
- снижение иммунитета из-за имеющихся инфекционных заболеваний;
- нарушения менструального цикла;
- частое использование ежедневных прокладок;
- постоянные стрессы;
- применение медикаментов, которые приводят к нарушению микрофлоры влагалища;
- ношение синтетического нижнего белья.
Следует отметить, что в группу риска входят женщины, которые:
- имеют гиповитаминоз или авитаминоз;
- часто используют спринцевание;
- проводят лучевую или химиотерапию;
- злоупотребляют алкоголем;
- не соблюдают правил гигиены;
- имеют воспалительные процессы во влагалище;
- болеют сахарным диабетом.
В 75% случаев гарднереллез возникает уже на фоне других имеющихся урогенитальных недугов.
Терапия
Для сохранения здоровья важно вовремя распознать симптомы у женщин и начать лечение гарднереллеза. Если болезнь диагностирована на ранней стадии, то продолжительность терапии составляет не более 7 дней. За это время необходимо решить две основные задачи:
- Избавиться от избыточного количества вредоносных бактерий.
- Восстановить природную микрофлору влагалища.
Основной методикой, как полностью вылечить гарднереллу становится применение медикаментов. Одновременно с этим нужно скорректировать образ жизни. Важно отказаться от вредных привычек и направить все усилия на стимулирование работы иммунной системы.
В плане лечебных мероприятий должна стоять и диета. Ежедневное меню составляется преимущественно из растительных продуктов. От жирных и жареных блюд, копченостей, маринадов, полуфабрикатов и фаст-фуда следует полностью отказаться. На восстановлении микрофлоры положительно влияет употребление кисломолочной продукции. Избежать повышения уровня сахара в крови поможет отказ от кондитерских изделий и всевозможной выпечки.
Спустя неделю после завершения курса терапии сдаются повторные анализы. Они позволят проконтролировать, насколько эффективным оказалось медикаментозное лечение. Еще раз пройти обследование придется через месяц, чтобы убедиться в отсутствии рецидива.
Во время беременности избавиться от гарднереллеза крайне сложно. Применять антибактериальные препараты будущим мамам запрещено, а без них победить бактерии невозможно. Поэтому в процессе родоразрешения болезнетворные микроорганизмы могут легко передаваться ребенку. Появившись в теле, они никак себя не проявляют. Для развития болезни необходимо воздействие неблагоприятных факторов.
Возможные осложнения
Бактерия Gardnerella vaginalis относится к условно патогенным микроорганизмам. Это означает, что опасности для жизни она в себе не несет.
Но, нарушая микрофлору влагалища и убивая полезные лактобактерии, она освобождает место для других патогенных микроорганизмов.
К осложнениям гарднереллеза относят:
- вагинит, переходящий в кольпит;
- кишечный дисбактериоз;
- эндометриоз (возникает, если патологический процесс диагностируется на матке);
- аднексит (воспаление яичников и маточных труб).
Чтобы не допустить подобных осложнений, важно провести раннюю диагностику гарднереллеза. Поэтому при появлении малейших симптомов недуга следует сразу же обратиться к врачу.
Классификация
Как и большинство болезней, поражающих женскую мочеполовую систему, гарднереллез имеет определенную классификацию. Врачи-гинекологи чаще классифицируют заболевание по тяжести протекания:
- бактериальный вагиноз компенсированного типа — при таком течении по анализам отмечается незначительное наличие условно-патогенной флоры у больных;
- бактериальный вагиноз по субкомпенсированному типу — значительно уменьшается количество полезных лактобактерий с повышением условно-патогенной флоры, в том числе гарднереллы;
- вагиноз по декомпенсированному типу — полезная флора практически полностью вытеснена патогенной, воспалительный процесс сильный, выраженный, характерны изменения эпителиального слоя.
Пути передачи гарднереллеза
Заболеванием можно заразиться при половом контакте. В группу риска входят женщины, ведущие беспорядочную интимную жизнь.
Заражение бактерией Gardnerella vaginalis является практически невозможным при оральном сексе. Это связано с неустойчивостью микроорганизма к развитию в полости рта и глотки. Единственным исключением являются моногамные женские отношения с вагинально-оральными контактами.
Кроме того, заболевание передается от инфицированной матери к ребенку или в результате внутриутробного заражения.
Особенности течения болезни у беременных
Если женщина во время вынашивания ребенка ведет беспорядочную половую жизнь, то возможно заражение гарднереллезом. Инкубационный период заболевания составляет 6-10 дней. Стоит учесть, что иммунитет женщины в это время ослабленный, что позволяет бактериям быстро размножаться, соответственно, болезнь прогрессирует.
Возможна ситуация, когда патология проявляется только во время беременности, хотя беспорядочных связей у женщины не было. Это значит, что заразилась она ранее, а на фоне ослабленного иммунитета либо же сильных переживаний и постоянных стрессов бактерия активировалась.
Как влияет гарднерелла на плод во время беременности
Так как Gardnerella vaginalis не способна проникать через плаценту, она не имеет прямого влияния на малыша. Но сопутствующие симптомы и заболевания могут вызывать некоторые проблемы:
- при сильной степени поражения влагалища бактерией на первых неделях беременности нарушаются процессы развития ребенка, из-за чего возможны недоразвитие каких-либо органов или же другие аномалии;
- вследствие воспалительного процесса наступают преждевременные роды (это связано с отеком, из-за которого повышается тонус матки);
- на фоне нарушения микрофлоры влагалища и ослабленного иммунитета возможно заражение другими урогенитальными инфекциями с более тяжелыми последствиями;
- при естественных родах ребенок может также заразиться гарнереллезом.
Прерывать беременность из-за этого недуга не стоит. Необходимо вовремя начать терапию, чтобы не вызвать осложнений, которые появляются при прогрессировании заболевания. Gardnerella vaginalis поддается лечению у беременных женщин. Обычно врач назначает антибактериальную терапию, а также иммуномодуляторы и витаминные комплексы. Стоит отметить, что беременным лучше использовать не таблетированные лекарственные препараты, а вагинальные свечи.
Основные причины возникновения
Вытеснение полезной микрофлоры условно-патогенной бактерией – это главное условие появления заболевания. Специалисты в области медицины уверены в том, что решающим фактором, провоцирующим возникновение гарднереллёза у мужчин и женщин, являются особенности половой жизни. Ведь у девственников и девственниц подобный недуг никогда не диагностируется, равно как и у сексуально активных женщин, не страдающих вагинитом. Заболеть гарднереллёзом женщина может, если:
- Половая жизнь ведётся регулярно, и без соблюдения моральных норм.
- Организм уже подвергался атаке венерических инфекций.
- Имеются проблемы с менструальным циклом.
- Длительное время используются внутриматочные или оральные контрацептивы.
- Женщина злоупотребляет ношением «эротического» белья, которое, зачастую, изготавливается из
- синтетических материалов.
- Правила интимной гигиены не соблюдаются должным образом.
- В рационе отсутствуют кисломолочные продукты.
- Уже имеется какое-либо венерическое заболевание.
- Проявились эндокринные нарушения, к числу которых относятся беременность и роды.
- Организм находится в состоянии физического или эмоционального переутомления.
- Спринцевание проводится слишком часто, и в процессе участвуют хлорсодержащие препараты.
Выявление гарднереллеза
Диагностируется Gardnerella vaginalis довольно просто. Для того чтобы обнаружить заболевание, женщине необходимо обратиться к гинекологу.
Доктор проведет осмотр пациентки и по характеру выделений и рыбному запаху сможет предположить патологию. Но так как бывают случаи бессимптомного течения заболевания, нужно сдать определенные анализы.
Для подтверждения гарднереллеза берут обычный мазок, а затем его микроскопируют. Врач может измерить pH влагалища (если в норме среда кислая, то при поражении бактерией становится щелочной).
Из дополнительных методов диагностики врач назначает реакцию на изонитрил (подтверждение заболевания по запаху протухшей рыбы) и общий анализ крови, в котором будет выявлено увеличение количества лейкоцитов.
Более дорогие методы исследования обычно не используются, поскольку они лишь подтверждают наличие того или иного микроорганизма во влагалище. А в норме, как уже известно, даже у абсолютно здоровой женщины Gardnerella vaginalis может находиться во влагалище, но в малом количестве.
Диагностика
Перед началом лечения гарденелеза больной должен пройти все необходимые диагностические процедуры. Это является очень важным условием для полноценного выздоровления, так как гарденелез может быть вторичной инфекцией на фоне другого заболевания. Сначала необходимо сдать анализы на обнаружение венерической болезни. У мужчин дальнейшая диагностика проводится по такому алгоритму:
- Проводят лабораторное исследование выделений. При наличии множества лейкоцитов, что говорит о воспалении, мочеиспускательный канал путем малоинвазивных средств визуализации не исследуют. Раздраженные стенки уретры легко повредить при манипуляциях.
- Оценивается состояние предстательной железы с помощью ректальной пальпации и ультразвукового исследования.
- Проводится микроскопия жидкости из предстательной железы.
Гарденелез у женщин диагностируется при помощи взятия мазка, и исследования его под микроскопом. Возможно использование метода бактериального посева, что позволяет комплексно обнаружить наличие и других патогенных бактерий. Если бактериоскопия подтверждает диагноз, лечение начинать нужно немедленно.
Лечение заболевания
Терапия гарднереллеза включает в себя целую схему.
Первый этап
Изначально нужно уничтожить лишнее количество гарднерелл в женских половых путях. С этой целью назначают антибиотики. Среди популярных лекарственных средств выделяют Метронидазол и Клиндамицин. Препараты выпускаются в форме таблеток, свечей, мазей, гелей. Принцип их действия является практически одинаковым: они подавляют рост и размножение бактерий. Если через семь дней после лечения одним из этих антибиотиков улучшения не наступает, врач заменяет его другим.
Нетрадиционная медицина
Стоит отметить, что лечить заболевание народными средствами необходимо только после консультации с врачом.
Способ №1
Следует приготовить настой из шалфея. Для этого нужно взять 1 ст. л. измельченного растения и залить 1 л кипятка. Далее, отвар настаивается в течение трех часов.
Принимать настой следует два раза в день по полстакана.
Способ №2
Необходимо смешать листья фиалки, кору дуба, полынь, ромашку в одинаковых количествах. Далее, полученную смесь нужно залить кипятком и дать настояться. После процеживания отвар следует использовать для спринцеваний. Их необходимо проводить два раза в сутки утром и вечером.
Способ №3
Можно приготовить настой для приема внутрь из листьев березы, травяного сбора ромашки, пустырника, чабреца и мяты. Смесь также заливается кипятком и настаивается в течение 2-3 часов. Спустя время можно начинать принимать отвар по одному стакану в день.
Используя народные средства в комплексе с медикаментозной терапией, результат лечения будет намного эффективней.
Профилактика патологии
Для того чтобы снизить риск заражения гарднереллезом или исключить рецидив заболевания, следует соблюдать некоторые рекомендации:
- избегать случайных половых связей;
- при наличии других урогенитальных недугов сразу же обращаться к врачу;
- носить нижнее белье из натуральных тканей;
- отказаться от постоянного использования ежедневных прокладок (так как они закрывают проход воздуха, создавая благоприятные условия для размножения патогенных бактерий);
- при сомнительных половых контактах использовать средства защиты;
- соблюдать правила личной гигиены;
- следить за состоянием иммунитета;
- дважды в год проходить профилактический гинекологический осмотр.
Кроме того, женщине рекомендуются избегать переохлаждения, чрезмерных физических нагрузок и стрессов.